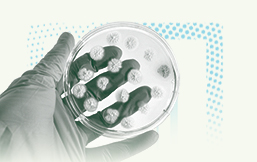

נעים להכיר
בר-אילן נמנית עם האוניברסיטאות הגדולות בישראל, והיא גם האוניברסיטה הצומחת ביותר בשמונה השנים האחרונות, במספר הסטודנטים והסטודנטיות שלה, וכל זאת לא במקרה. בר-אילן מצטיינת במחקר ובהוראה, היא מקיימת קשרים ענפים עם התעשייה והקהילה, והקמפוס הירוק והמטופח שלה מקדם חוויית לימודים נעימה ומפרה.

21,200
סטודנטים

10
פקולטות

20
ספריות
47
מכוני מחקר

1955
שנת הקמה

מחזון למציאות
ציוני דרך היסטוריים
דרך ארוכה עברה אוניברסיטת בר-אילן מאז הקמתה בשנות החמישים של המאה הקודמת. לאורך כל הדרך חותרת האוניברסיטה למצוינות מדעית ואינטלקטואלית, השזורה בערכי המסורת היהודית ומורשת ישראל.










